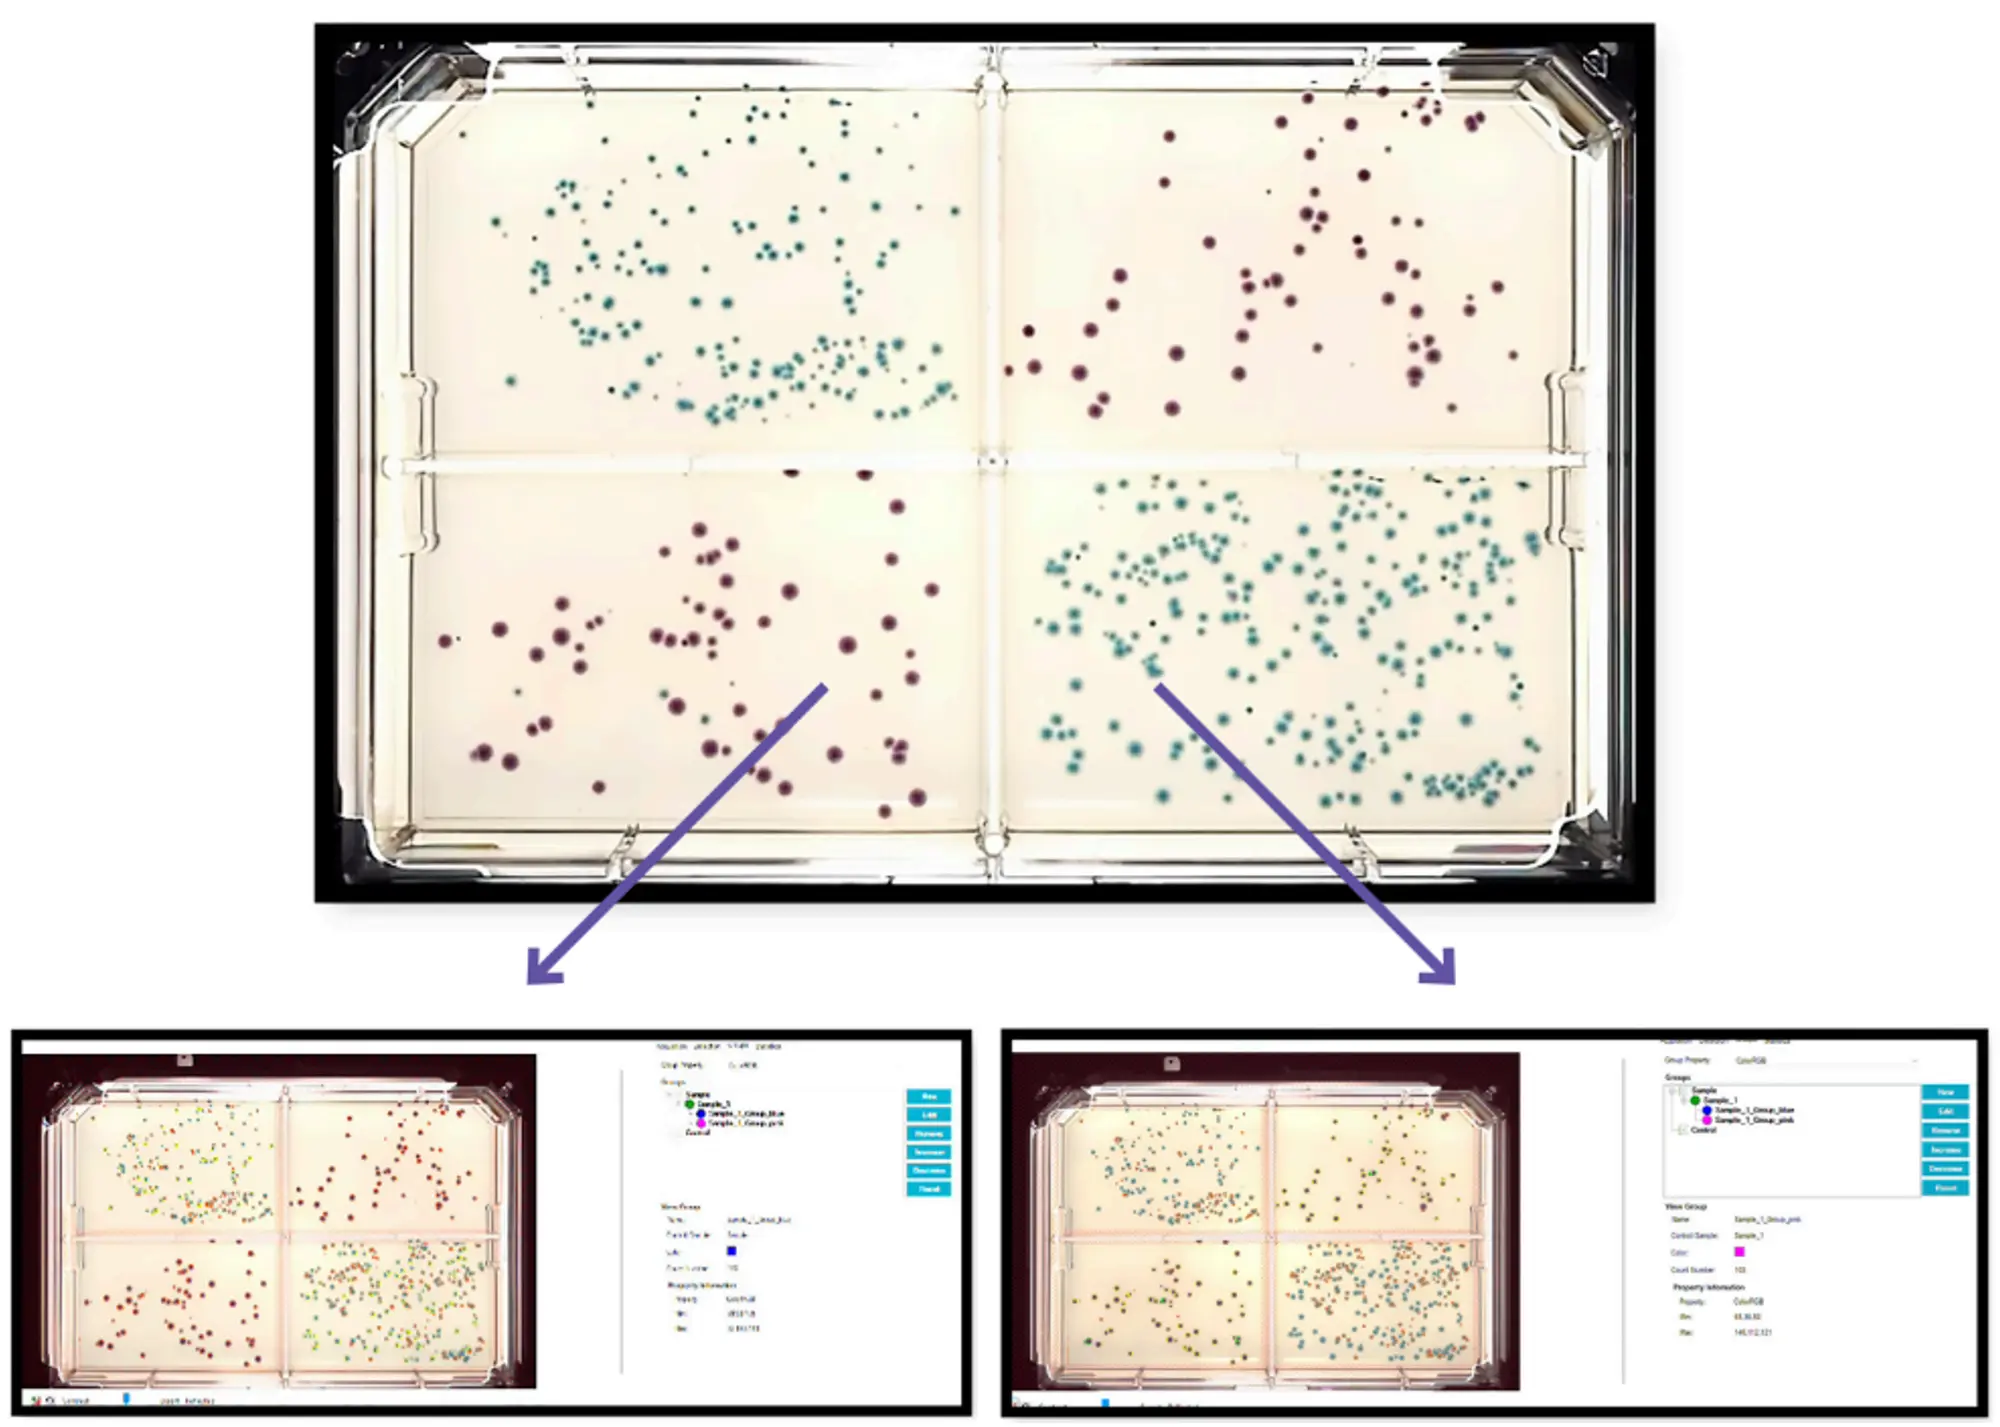

2025/10/9
手と頭を解放する:自動化が微生物研究を変革する方法
Insider Insights:Dr. Sushmita Sudarshan
微生物学の博士号を持ち、長年ラボで実験を重ねてきたSushmita Sudarshanは、プレートへのピペッティングやコロニーの手作業でのピッキングに何時間も費やすことがどういうことか、誰よりもよく理解しています。現在、QPix® FLEX™ 微生物コロニーピッカーのような自動化ソリューションに取り組む科学者として、彼女はこうした骨の折れる手作業のワークフローを、効率的で無菌性が保たれ、再現性の高いプロセスへと変革しています。
この「Insider Insights」シリーズでは、専門家が「次に備えるために科学者に何が必要か」について、率直な意見と深い考察を共有します。今回、Sushmitaは、自動化がラボやデータだけでなく、科学を支える人々にとって何を意味するのかを振り返ります。研究者がルーチン作業に費やす時間を減らし、世界を変える可能性を秘めた複雑な生物学的課題の探求により多くの時間を割けるようになること――それが自動化の本質です。
知りたいことは?
- 自動化の進展が微生物研究において、どのように顧客の日常業務を改善してきたと感じますか?
- なぜこれが魅力的だと思いますか?
- この分野でのイノベーションを促したトレンドや顧客からのフィードバックは何ですか?
- 現在、顧客が直面している一般的な研究課題と、自動化が微生物研究にどのような新しい機会をもたらすでしょうか?
- 微生物研究における自動化が最大限に活用される世界では、次に何が起こると考えますか?
自動化の進展が微生物研究において、どのように顧客の日常業務を改善してきたと感じますか?
率直な感想(Quick reaction):自動化は、研究者に「信頼できるラボパートナー」を与えるようなものです。決して手順を忘れず、すべてを無菌に保ち、実験を確実に進めます。
深い考察(Deep reflection):微生物研究は、抗生物質の探索やマイクロバイオーム解析から、合成生物学や持続可能な製造に至るまで、あらゆる分野の基盤となっています。これらの分野は、複雑で反復的なワークフローを必要とし、無菌性と精度を維持することが不可欠です。なぜなら、扱う対象は細菌、ウイルス、ファージなどであり、コンタミネーションのリスクが非常に高いからです。これらのワークフローは、時間に敏感で反復的であるだけでなく、人為的なエラーが起こりやすいという特徴があります。嫌気性菌、糸状菌株、胞子形成菌などを扱う場合、無菌性やトレーサビリティのわずかな欠落が、実験全体を台無しにする可能性があります。
「微生物学は、抗生物質から合成生物学まで幅広く関わっており、自動化は、誰が操作してもワークフローを一貫して進めることを可能にします」。
自動化は、ピペッティング、コロニーピッキング、プレーティングといった重要で手作業が必要な工程を担います。これらはすべて、コンタミネーションを減らし、トレーサブルな記録を保持し、再現性を確保するための制御されたチャンバー内で行われます。特に私が興奮しているのは、QPix FLEXシステムのような革新により、このレベルの精度が、規模の大小を問わず、すべてのラボで利用可能になったことです。小規模なラボから、世界的な企業まで、大きな課題に取り組むことができるのです。

QPix FLEX 微生物コロニーピッカーは、低酸素チャンバー内外でエンドツーエンドの自動化を提供します。
お客様にとって、これはスループットの向上、データ生成の高速化、失敗実験の減少、そしてトラブルシューティングではなく探索により多くの時間を割けることを意味します。ライブラリスクリーニングを実施する場合でも、単一株の最適化を行う場合でも、QPix FLEXシステムは、ラボの規模に関わらず、複雑さを増やすことなくインパクトを拡大することを可能にします。
なぜこれが魅力的だと思いますか?
率直な感想(Quick reaction):これが魅力的なのは、私自身がこの作業を手作業で行ってきた経験があり、その負担がどれほどエネルギーを消耗し、創造的に考えたり、協働したり、本当に情熱を注げる問いを追求する余裕を奪うかを身をもって知っているからです。QPix FLEXシステムは単なる自動化ではありません。それは研究者をエンパワーします。コロニーピッキング、ストリーク、イメージングを効率化することで、手作業の負担から研究者を解放し、より重要なこと――スマートな実験設計、より高度なアッセイの実施、微生物イノベーションの限界を押し広げること――に集中できる時間と明晰さを取り戻します。
深い考察(Deep reflection):博士課程の間、私は96ウェルプレートに培地をピペッティングしたり、コロニーを手作業でプレーティングしピッキングすることに無数の時間を費やしました。これらの作業は微生物ワークフローの完全性と成功に不可欠であり、精度、一貫性、注意を要します。しかし、それらは時間を要し、繰り返しが多いため、科学者を進歩を推進する本来の仕事――実験設計、データ解釈、イノベーションの推進――から遠ざけてしまいます。これらのステップを自動化することで、研究者は自分の得意分野に集中できるようになります。大胆な問いを立て、複雑な問題を解決し、科学を前進させることです。
「もし博士課程のときに自動化があったなら、私は働く時間を減らしたのではなく、よりスマートに働けたでしょう。QPix FLEXのようなシステムの精度と一貫性は、より複雑な仮説を探求し、よりクリーンなデータセットを生成し、発見のスピードを加速する助けになったはずです。自動化は科学的厳密さを置き換えるものではありません。それを強化するものです」。
科学者がルーチン作業を自動化するツールを手にしたとき、彼らはブレークスルーを生み出す創造的かつ戦略的な仕事に集中できるようになります。私のお気に入りの例をいくつか挙げると、微生物によるインスリン生産があります。かつては動物の膵臓から抽出されていたインスリンが、現在では組換えDNA技術によって設計されたE.coliによって合成されています。これは、研究者が革新する時間を持てたからこそ実現した飛躍です。もう一つは、Pseudomonas株を用いた生分解性プラスチックの開発で、石油化学ポリマーに代わる持続可能な選択肢を提供します。
これらは単なる技術的な勝利ではありません。好奇心、創造性、そして探求する時間から生まれたパラダイムシフトです。それこそが、自動化の真の力だと私は考えます。科学者に想像し、革新し、次を発見するための時間を取り戻すのです。
QPix FLEXワークセルは、コロニーピッキング、単一コロニーのストリーク、液体ハンドリングを自動化することで、合成生物学、マイクロバイオーム研究、タンパク質工学、食品安全におけるアッセイの基盤となるワークフローを効率化します。高解像度カラーイメージングシステムにより、形態やRGBカラー強度に基づくコロニーの正確な分類が可能となり、表現型に基づく選択や微生物多様性スクリーニングに特に有用です。0.2 mmという微小なコロニーを検出し、視覚的特徴でグループ化できるため、色素産生、酵素活性、抗生物質耐性のスクリーニングなど、より精緻なアッセイを実施できます。
例えば合成生物学では、QPix FLEXは遺伝子改変株のハイスループットスクリーニングをサポートし、成功したコンストラクトの迅速な特定を可能にします。マイクロバイオームカルチュロミクスでは、嫌気条件への対応により、低酸素環境で生育する難培養性微生物の分離と特性評価が可能です。タンパク質発現アッセイでは、ヒットピッキングや培地分注を自動化し、高収量クローンの特定を加速します。これは単なるツールではありません――科学を加速するためのプラットフォームです。
4分割OmniTrayにプレーティングされた青色のE.coliコロニーとピンク色のKlebsiella aerogenesコロニーのグループ化。画像出典:QPix FLEX微生物コロニーピッカーが微生物研究とスクリーニングにおける効率的な色ベースのコロニーグループ化を実現する方法を説明したアプリケーションノート。
自動化は、科学者に「可能性を再構築する自由」を与え、それがブレークスルーを生み出す原動力となります。だからこそ、私はこの技術に強く魅力を感じます。科学者が繰り返し作業の負担から解放されると、想像し、革新し、次を発見する力が生まれます。それこそが、自動化の真の力だと私は考えます。
この分野でのイノベーションを促したトレンドや顧客からのフィードバックは何ですか?
率直な感想(Quick reaction):科学者たちが教えてくれたのは、彼らを本当に遅らせる要因です。それは、無菌性の問題、しつこいコンタミネーション、低酸素チャンバーで互換性がない、あるいは監視が必要な機器、そして既存のワークフローに適合しないツール――私たちはその声に耳を傾けました。
深い考察(Deep reflection):微生物ワークフローにおける無菌性は、単なるベストプラクティスではありません。それは生存戦略です。特にClostridiumやBacillusのような胞子形成菌、あるいは空気中に残留しプレート間で交差汚染を引き起こすエアロゾルを生成しやすい微生物を扱う場合にはなおさらです。従来の金属製ピッキングピンは再利用可能ですが、各ラン(処理サイクル)間での徹底的な洗浄が必要であり、場合によってはそれでも不十分なことがあります。この課題に対応するため、QPix FLEXシステムは滅菌済みの使い捨てピッキングピンを導入しました。これにより、ピンの滅菌が不要となり、キャリーオーバーによるコンタミネーションのリスクを低減します。さらに、ラン間で表面の微生物負荷を減らすUV除染を組み合わせることで、最小限の手動介入でコンタミネーションリスクを最小化します。

ピッキング工程におけるソースプレートのピック前(A)およびピック後(B)の画像。ピックされたコロニーはImageJソフトウェアでカウント(C)。画像出典:QPix FLEX微生物コロニーピッカーが、コンタミネーションのない環境でコロニーピッキングの精度と効率を確保し、微生物のクロストランスファーを防ぐ方法を説明するアプリケーションノート。
たとえば、糞便や土壌サンプルから数百のコロニーを分離するマイクロバイオームカルチュロミクスでは、わずかなコンタミネーションでも下流のシーケンス結果を歪める可能性があります。使い捨てピンは単回使用の無菌性を確保し、スループットを損なうことなくサンプルの完全性を維持します。
柔軟性も重要なテーマです。科学者たちは、厳格な装置仕様に合わせてプロトコールを全面的に変更することを望んでいませんでした。QPix FLEXシステムは、ユーザー定義のプレートマップやコロニー形態パラメータ(エッジの鮮明度、円形度、色コントラストなど)をサポートする適応型ソフトウェアで対応しました。これにより、研究者は希少株や成長の遅いコロニー、あるいはエンジニアリングされたコロニーに対して選択基準を微調整できます。
バーコードトラッキングによるラベルミス防止です。ラン中のラベル誤りを防ぐため、バーコード追跡機能が追加されました。たとえば、エンジニアリングされたE.coli変異株をスクリーニングするラボでは、バーコードにリンクされたメタデータを使用して、コロニーの由来、培養条件、プラスミド構築情報を追跡できます。これにより、プレートからフリーザーストックまで完全なトレーサビリティが保証されます。
これらのアップグレードは理論上のものではなく、顧客からの直接のフィードバックに基づいています。そして、QPix FLEXシステムは単なるコロニーピッカーではありません。それは、科学者が日々直面する微妙で現実的な課題に応えるソリューションです。
「イノベーションは孤立した環境では生まれません。科学者の声に耳を傾け、『これが私たちの仕事を難しくしている』という現実を理解することから始まります」。
現在、顧客が直面している一般的な研究課題と、自動化が微生物研究にどのような新しい機会をもたらすでしょうか?
率直な感想(Quick reaction):手作業はエラーと不一致を招きます。上流での小さなミスが、下流で数か月分の努力を無駄にすることがあります。
深い考察(Deep reflection):率直に言えば、ラボでの手作業は退屈なだけでなく、リスクが伴います。液体培地や培養サンプルを何十枚ものプレートにピペッティングしたことがあるなら、その瞬間を知っているはずです。30枚目に差し掛かる頃には、手が痙攣し、集中力が途切れ、サンプルAをウェルBに入れたのかCに入れたのか分からなくなる。その小さなミスが、数週間の作業を台無しにします。シーケンス準備、MALDI-TOF解析、タンパク質工学—すべてが一つの上流エラーで損なわれます。私も経験しました。それは苛立たしく、コストがかかり、完全に回避可能な問題です。
「ピペットの一度のミスが、プロジェクト全体を台無しにすることがあります。自動化はエラーを減らし、すべてのサンプル、すべてのプレート、すべての時間を守ります」。
だからこそ、自動化は単なるスピードの問題ではありません。それは科学的なレジリエンスを可能にします。すべてのコロニーが正確にピックされ、液体が精密に処理され、すべてのプレートバーコードが追跡され、すべてのステップが記録されるとき、あなたは単に速く作業しているだけではありません。トレーサブルで再現性があり、スケーラブルなワークフローを構築しているのです。
QPix FLEX微生物コロニーピッカーを使用すれば、プレーティング、ストリーク、ピッキング、ヒットピッキング、液体ハンドリングが1台のコンパクトな装置で完全自動化され、1日最大8時間の作業時間を削減し、一貫性のある再現性の高い結果を保証します。
これは今まで以上に重要です。微生物研究は、菌株エンジニアリング、抗生物質探索、プロバイオティクス開発において限界を押し広げています。これらのプロジェクトでは「だいたい良い」では不十分です。再現性は必須条件です――規制承認のため、科学的信頼性のため、そして研究者自身の安心のために。自動化は、潜在的なエラーが起こりうるラボを、確信を持って革新できるプラットフォームへと変えます。そして、ブレークスルーが起きたとき、それが厳密さと信頼性の基盤の上に築かれることを保証します。
微生物研究における自動化が最大限に活用される世界では、次に何が起こると考えますか?
率直な感想(Quick reaction):私は、すべてのラボ――大規模でも小規模でも――が、柔軟で信頼性の高い自動化にアクセスできることで、ブレークスルーに貢献できる未来を思い描きます。
深い考察(Deep reflection):真の可能性とは、より複雑なシステムを構築しながら、同時にアクセスを民主化することです。今日、最も優れたアイデアのいくつかは小規模な学術ラボから生まれています。しかし、自動化がなければ、それらのアイデアをどこまで発展させられるかは限られています。もしすべてのラボが、大規模な資金を必要とせずに、高品質で再現性のある実験を実施できるツールを持っていたらどうでしょう。
私が思い描くのは、自動化が「贅沢品」から「インフラ」へとシフトする未来です。微生物研究のラボが――規模に関係なく――柔軟でモジュール式のシステムにアクセスできるようになれば、小規模な学術ラボから大手製薬企業やバイオテック企業まで、実験能力に真の公平性が生まれます。コロニーピッキングとヒット選択、メタデータのトレーサビリティ、無菌サンプル調製といった統合自動化により、研究者は高精度なスクリーニングを実行し、ヒットを迅速に検証し、再現性を損なうことなくプロトコールをスケールできます。
「私にとって、真の可能性とは、すべてのラボ――その規模に関係なく――が信頼性の高い、インパクトのある実験を実施し、世界的な課題の解決に貢献できることです」。
容量を増やすだけでなく、複雑な生物学的課題を支える一貫性とトレーサブルなワークフローを実現することも重要です。目的が抗生物質探索であれ、合成経路の最適化であれ、菌株の特性評価であれ、自動化はラボの優先事項――スループット、無菌性、プラットフォーム統合――に適応する必要があります。これこそが、トランスレーショナルサイエンスへの幅広い参加を可能にし、緊急の微生物課題に対するソリューション開発を加速する方法です。例えば、耐性が高まる中での新しい抗生物質の迅速な探索や、すべての人に利益をもたらすバイオ製品の迅速な開発です。ツールが多様なニーズに適応できれば、より多様で創造的な研究が生まれ、複雑な生物学的問題に対する解決策が増えるでしょう。
詳細なインサイトをさらに知りたい方は、Sushmitaが同僚のDr. Sheela Muleyと共に開催したウェビナーをご覧ください。このウェビナーでは、スマートな自動化によって嫌気性マイクロバイオーム研究における精度をどのように実現するかを紹介しています。
Dr. Sushmita Sudarshan
Dr. Sushmita Sudarshanは、モレキュラーデバイスでアッセイ開発部門のアプリケーションサイエンティストを務めています。テキサス大学ダラス校で分子生物学の博士号を取得し、微生物研究、アッセイ開発、ラボ自動化において10年以上の専門知識を有しています。彼女のキャリアは学術機関と産業界の両方にわたり、Isolation Bioでの勤務を経て、現在はモレキュラーデバイス社でバイオアナリティカル機器の開発を推進し、微生物および哺乳類ワークフローにおける自動化を支援しています。
Dr. Sudarshanは、複雑なアッセイの統合と検証を専門とし、製品イノベーションを推進するとともに、科学者との協働を通じて、最適化されたハイスループットソリューションによる発見の加速に貢献しています。

